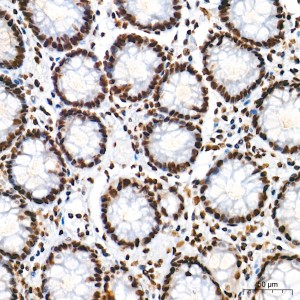
KD-Validated hnRNP A2B1 Rabbit mAb (20 μl)

KD-Validated hnRNP A2B1 Rabbit mAb (20 μl)
| Reactivity: | Human, Mouse, Rat |
| Applications: | WB, IHC, IF/IC, ELISA |
| Host Species: | Rabbit |
| Isotype: | IgG |
| Clonality: | Monoclonal antibody |
| Gene Name: | heterogeneous nuclear ribonucleoprotein A2/B1 |
| Gene Symbol: | HNRNPA2B1 |
| Synonyms: | RNPA2; HNRPA2; HNRPB1; SNRPB1; HNRNPA2; HNRNPB1; IBMPFD2; HNRPA2B1 |
| Gene ID: | 3181 |
| UniProt ID: | P22626 |
| Immunogen: | A synthetic peptide corresponding to a sequence within amino acids 151-250 of human HNRNPA2B1 (NP_112533.1). |
| Dilution: | WB 1:13000-1:78000; IHC 1:3000-1:30000; IF/IC 1:200-1:2000 |
| Purification Method: | Affinity purification |
| Concentration: | 1.37 mg/ml |
| Buffer: | PBS with 0.09% Sodium azide, 0.05% BSA, 50% glycerol, pH7.3. |
| Storage: | Store at -20°C. Avoid freeze / thaw cycles. |
| Documents: | Manual-HNRNPA2B1 monoclonal antibody |
Background
This gene belongs to the A/B subfamily of ubiquitously expressed heterogeneous nuclear ribonucleoproteins (hnRNPs). The hnRNPs are RNA binding proteins and they complex with heterogeneous nuclear RNA (hnRNA). These proteins are associated with pre-mRNAs in the nucleus and appear to influence pre-mRNA processing and other aspects of mRNA metabolism and transport. While all of the hnRNPs are present in the nucleus, some seem to shuttle between the nucleus and the cytoplasm. The hnRNP proteins have distinct nucleic acid binding properties. The protein encoded by this gene has two repeats of quasi-RRM domains that bind to RNAs. This gene has been described to generate two alternatively spliced transcript variants which encode different isoforms.
Images
 | Western blot analysis of various lysates using [KD Validated] hnRNP A2B1 Rabbit mAb (A27189) at 1:13000 dilution incubated overnight at 4℃. Secondary antibody: HRP-conjugated Goat anti-Rabbit IgG (H+L) (AS014) at 1:10000 dilution. Lysates/proteins: 25 μg per lane. Blocking buffer: 3% nonfat dry milk in TBST. Detection: ECL Basic Kit (RM00020). Exposure time: 10s. |
 | Western blot analysis of lysates from wild type (WT) and hnRNP A2B1 knockdown (KD) HeLa cells using [KD Validated] hnRNP A2B1 Rabbit mAb (A27189) at 1:13000 dilution incubated overnight at 4℃. Secondary antibody: HRP-conjugated Goat anti-Rabbit IgG (H+L) (AS014) at 1:10000 dilution. Lysates/proteins: 25 μg per lane. Blocking buffer: 3% nonfat dry milk in TBST. Detection: ECL Basic Kit (RM00020). Exposure time: 10s. |
 | Immunohistochemistry analysis of paraffin-embedded Human colon tissue using [KD Validated] hnRNP A2B1 Rabbit mAb (A27189) at a dilution of 1:7000 (40x lens). High pressure antigen retrieval performed with 0.01M Tris-EDTA Buffer (pH 9.0) prior to IHC staining. |
 | Immunohistochemistry analysis of paraffin-embedded Human pancreas tissue using [KD Validated] hnRNP A2B1 Rabbit mAb (A27189) at a dilution of 1:7000 (40x lens). High pressure antigen retrieval performed with 0.01M Tris-EDTA Buffer (pH 9.0) prior to IHC staining. |
 | Immunohistochemistry analysis of paraffin-embedded Mouse testis tissue using [KD Validated] hnRNP A2B1 Rabbit mAb (A27189) at a dilution of 1:7000 (40x lens). High pressure antigen retrieval performed with 0.01M Tris-EDTA Buffer (pH 9.0) prior to IHC staining. |
 | Immunohistochemistry analysis of paraffin-embedded Rat brain tissue using [KD Validated] hnRNP A2B1 Rabbit mAb (A27189) at a dilution of 1:7000 (40x lens). High pressure antigen retrieval performed with 0.01M Tris-EDTA Buffer (pH 9.0) prior to IHC staining. |
 | Immunohistochemistry analysis of paraffin-embedded Rat colon tissue using [KD Validated] hnRNP A2B1 Rabbit mAb (A27189) at a dilution of 1:7000 (40x lens). High pressure antigen retrieval performed with 0.01M Tris-EDTA Buffer (pH 9.0) prior to IHC staining. |
 | Confocal imaging of HeLa cells using [KD Validated] hnRNP A2B1 Rabbit mAb (A27189, dilution 1:200) followed by a further incubation with Cy3 Goat Anti-Rabbit IgG (H+L) (AS007, dilution 1:500) (Red). The cells were counterstained with α-Tubulin Mouse mAb (AC012, dilution 1:400) followed by incubation with ABflo® 488-conjugated Goat Anti-Mouse IgG (H+L) Ab (AS076, dilution 1:500) (Green). DAPI was used for nuclear staining (Blue). Objective: 100x. |
You may also be interested in: